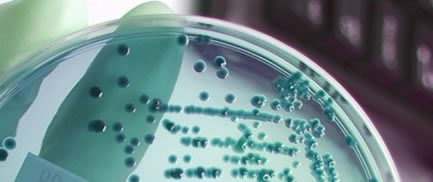

BACTERIAL GENOME: BG7 |
Complete BG7, the one stop shop for your bacterial genome: the genome of your bacteria in your hands
We offer now a new approach with Illumina and PacBio to obtain a cheap, accurate and completely assembled "de novo" bacterial genome !
COMPLETE BG7 SERVICE
Complete BG7 is a service providing you the complete solution for your bacterial genomics project. It includes all the phases of the project:

Project Design: understanding goals, choosing technologies, analyzing costs and turnaround times.
Sequencing: with the most appropriate technology for your project . PacBio, Illumina , Ion Torrent or 454
Assembly: with the better assembly pipeline for each technology or combination of technologies
Annotation with BG7: BG7 is our new method, specifically designed for bacterial genome annotation of NGS data published in PLOS ONE:
- http://dx.plos.org/10.1371/journal.pone.0049239
Customized Cloud Services: for managing and analyzing your genome data.
The prototype deliverables obtained for Escherichia coli K12 using BG7 system are available here
BG7 is a complete bacterial genome annotation system including exhaustive gene prediction integrated with rich functional annotation. It is especially designed for NGS data. All genes similar to any known gene from any organism can be detected. The system provides a complete genome annotation, even if the genome is fragmented in thousands of contigs.
You can get here some bacterial genomes that we have annotated with BG7.
- Tolerant to NGS-specific errors
- It detects genes with insertions, deletions or substitutions
- ORF prediction based on the detection of similarity with Uniprot proteins
- Customized to client specific goals: metabolic pathways, antibiotic resistance, vaccine devellopment,...
- A quick and complete annotated genome, close to manually annotated genomes
- Rich in functional annotations (GO, Interpro, EC, references)
- Deliverables compliant with freely available tools and browsers: Artemis, Mauve, EBI tools, Expasy tools, ...
- Annotation of one genome in one week
- Genome Express: annotation of one genome in one day!
Ask about our prices! Contact us: [email protected]
Hidden gems
- Non Gamstop Casinos
- Gioco Aviator
- Non Gamstop Casino
- Non Gamstop Casino
- Non Gamstop Casino
- Casino Italiani Non Aams
- Meilleur Casino En Ligne
- Best Online Casinos
- Non Gamstop Casino Sites UK
- Non Gamstop Casino UK
- Best Non Gamstop Casinos
- Gambling Sites Not On Gamstop
- UK Casinos Not On Gamstop
- Non Gamstop Casino Sites UK
- Casino Not On Gamstop
- Non Gamstop Casinos UK
- Casino Online Non Aams
- UK Casino Not On Gamstop
- UK Casinos Not On Gamstop
- Non Gamstop Casino UK
- Best Casinos Online
- Casino Online Non Aams
- Siti Di Slot Online
- Bitcoin Casino
- Casino En Ligne Crypto

 © Era7 Information Technologies SLU 2012 |
© Era7 Information Technologies SLU 2012 |